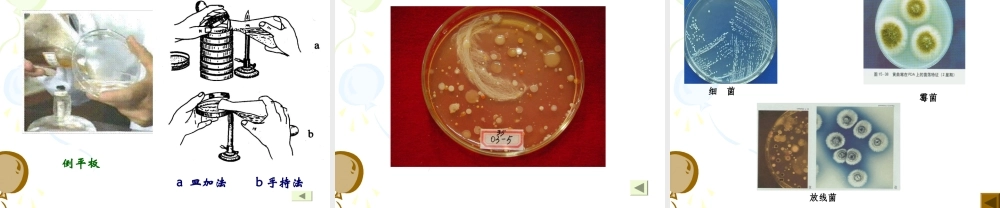
实验一（二）土壤中微生物的分离纯化及观察.ppt

实验一土壤中微生物的分离纯化及观察目的要求1.掌握倒平板的方法和几种常用的分离纯化微生物的基本操作技术。2.观察并识别微生物的菌落特征(群体形态)。基本原理从混杂的微生物群体中获得只含有某一种或某一株微生物的过程称为微生物的分离与纯化。1.简易单细胞挑取法(简易单孢子分离法)2.平板分离法选择适宜的培养基,微生物在固体培养基上生长形成的单个菌落可以是由一个或几个细胞繁殖而成的集合体。挑取单菌落可获得一种纯培养。方法:稀释涂布平板法、平板划线分离法器材分离源:自采集土壤样品培养基牛肉膏蛋白胨琼脂培养基,高氏Ⅰ号培养基、马丁氏(孟加拉红)培养基溶液或试剂盛4.5ml无菌水的试管,盛90ml无菌水并带有玻璃珠的三角烧瓶。仪器或其他用具振荡器,无菌培养皿,无菌吸管,接种环,电磁炉,培养箱,吸耳球等。1、编号:取无菌平皿18个。另取无菌水4支,依次标明10-2、10-3、10-4、10-5。2、倒平板:分别将三种培养基溶化后,冷却至55~60℃时,每种培养基各倒6皿,标注培养基名称。其中,高氏Ⅰ号培养基在倒入前需先添加10滴10%的苯酚。一、稀释涂布平板法(全组完成)3、制备土壤稀释液0.5ml各4.5ml无菌水各取稀释样0.1ml涂布放菌液时吸管尖不要碰到液面,即每一支吸管只接触一个稀释度。牛肉膏平板马丁氏平板10-210-310-410-510-110-210-310-410-50.5ml0.5m0.5ml高氏Ⅰ号平板4、涂布5、培养将高氏Ⅰ号平板、马丁氏平板倒置于28℃培养3~5d,牛肉膏蛋白胨平板倒置于37℃培养培养1~2d。6、菌落观察观察并描述土壤样品中分离到的细菌、放线菌、霉菌的菌落特征。7、挑菌落将培养出的单菌落进行斜面接种,并分别置37℃和28℃温室中培养,此后镜检是否为单一微生物。若有杂菌,继续分离纯化。二、平板划线分离法(个人完成)1、倒平板:将3种培养基溶化后,各倒一皿。并用记号笔标明培养基名称、样品编号、个人学号等。2、划线:分别挑取土壤样品中10-1的土壤悬液一环,在三种平板上划线,以分离细菌、放线菌、霉菌。分区划线、连续划线分区划线(适用于浓度较大的样品)连续划线(适用于浓度较小的样品)3、培养将高氏Ⅰ号平板、马丁氏平板倒置于28℃培养3~5d,牛肉膏蛋白胨平板倒置于37℃培养培养1~2d。4、菌落观察5、挑菌挑取单个菌落接种到斜面上培养,此后镜检是否为单一微生物。若有杂菌,继续分离纯化。实验结果(P34五、1.(2、3)你所做的涂布平板法和划线法是否较好地得到了单菌落?如果不...